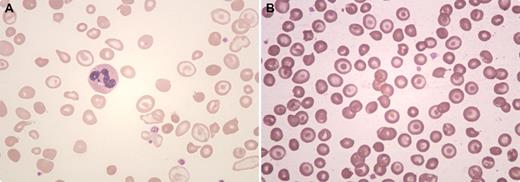
A 21-year-old woman presented with severe anemia and mild splenomegaly. Her complete blood cell count revealed a hemoglobin of 60 g/L, red cell count 2.8 × 1012/L, hematocrit 32%, MCV 114 fL, and MCH 21.4 pg. The reticulocyte count was 3.6%. The red cell indices suggested a macrocytic anemia. However, the peripheral smear (panel A) showed abundant macrocytic target cells, a few irregularly contracted red cells, polychromatophilia, macroovalocytes, and a few microcytes. In view of the target cells, high performance liquid chromatography was performed and a diagnosis of hemoglobin E disease was made. Her serum B12 level was 94 ng/L (normal range, 180-640 ng/L) with normal serum and red cell folate levels. A diagnosis of vitamin B12 deficiency with hemoglobin E disease was made. Her hemoglobin rose to 96 g/L after 2 weeks of supplementation of vitamin B12 and folate. / Hemoglobin E disease typically shows microcytic hypochromic anemia with target cells. The hematologic picture is best seen on this patient's follow-up peripheral smear (panel B). In this case, a vitamin B12 deficiency masked the underlying hemoglobinopathy, as determined by the automated cell counter. Other red cell abnormalities, such as thalassemia, may also be missed without a review of the peripheral smear.

A 21-year-old woman presented with severe anemia and mild splenomegaly. Her complete blood cell count revealed a hemoglobin of 60 g/L, red cell count 2.8 × 1012/L, hematocrit 32%, MCV 114 fL, and MCH 21.4 pg. The reticulocyte count was 3.6%. The red cell indices suggested a macrocytic anemia. However, the peripheral smear (panel A) showed abundant macrocytic target cells, a few irregularly contracted red cells, polychromatophilia, macroovalocytes, and a few microcytes. In view of the target cells, high performance liquid chromatography was performed and a diagnosis of hemoglobin E disease was made. Her serum B12 level was 94 ng/L (normal range, 180-640 ng/L) with normal serum and red cell folate levels. A diagnosis of vitamin B12 deficiency with hemoglobin E disease was made. Her hemoglobin rose to 96 g/L after 2 weeks of supplementation of vitamin B12 and folate.
Hemoglobin E disease typically shows microcytic hypochromic anemia with target cells. The hematologic picture is best seen on this patient's follow-up peripheral smear (panel B). In this case, a vitamin B12 deficiency masked the underlying hemoglobinopathy, as determined by the automated cell counter. Other red cell abnormalities, such as thalassemia, may also be missed without a review of the peripheral smear.
A 21-year-old woman presented with severe anemia and mild splenomegaly. Her complete blood cell count revealed a hemoglobin of 60 g/L, red cell count 2.8 × 1012/L, hematocrit 32%, MCV 114 fL, and MCH 21.4 pg. The reticulocyte count was 3.6%. The red cell indices suggested a macrocytic anemia. However, the peripheral smear (panel A) showed abundant macrocytic target cells, a few irregularly contracted red cells, polychromatophilia, macroovalocytes, and a few microcytes. In view of the target cells, high performance liquid chromatography was performed and a diagnosis of hemoglobin E disease was made. Her serum B12 level was 94 ng/L (normal range, 180-640 ng/L) with normal serum and red cell folate levels. A diagnosis of vitamin B12 deficiency with hemoglobin E disease was made. Her hemoglobin rose to 96 g/L after 2 weeks of supplementation of vitamin B12 and folate.
Hemoglobin E disease typically shows microcytic hypochromic anemia with target cells. The hematologic picture is best seen on this patient's follow-up peripheral smear (panel B). In this case, a vitamin B12 deficiency masked the underlying hemoglobinopathy, as determined by the automated cell counter. Other red cell abnormalities, such as thalassemia, may also be missed without a review of the peripheral smear.
For additional images, visit the ASH IMAGE BANK, a reference and teaching tool that is continually updated with new atlas and case study images. For more information visit http://imagebank.hematology.org.